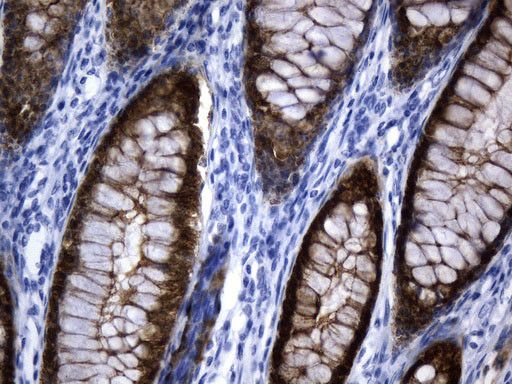
VIL1 Antibody in Immunohistochemistry (Paraffin) (IHC (P))

Search
OriGene
VIL1 Monoclonal Antibody (UMAB230), UltraMAB™
{{$productOrderCtrl.translations['antibody.pdp.commerceCard.promotion.promotions']}}
{{$productOrderCtrl.translations['antibody.pdp.commerceCard.promotion.viewpromo']}}
{{$productOrderCtrl.translations['antibody.pdp.commerceCard.promotion.promocode']}}: {{promo.promoCode}} {{promo.promoTitle}} {{promo.promoDescription}}. {{$productOrderCtrl.translations['antibody.pdp.commerceCard.promotion.learnmore']}}
图: 1 / 5
VIL1 Antibody (UM800122) in IHC (P)





产品信息
UM800122
种属反应
宿主/亚型
分类
类型
克隆号
抗原
偶联物
形式
浓度
纯化类型
保存液
内含物
保存条件
运输条件
靶标信息
Villin is part of cytoskeleton associated with the microvillar actin core bundle of gastrointestinal and renal brush border. It can interact with actin in a Ca2+ and phosphoinositide-regulated manner. Villin is a very specific marker for adenocarcinomas of the gastrointestinal tract and the pancreas. It is also expressed in some Merkel cell tumor and adenocarcinoma of the lung, prostate, ovarian and kidney.
仅用于科研。不用于诊断过程。未经明确授权不得转售。
篇参考文献 (0)
生物信息学
蛋白别名: OTTHUMP00000207159; unnamed protein product; Villin-1
基因别名: D2S1471; VIL; VIL1
UniProt ID: (Human) P09327
Entrez Gene ID: (Human) 7429